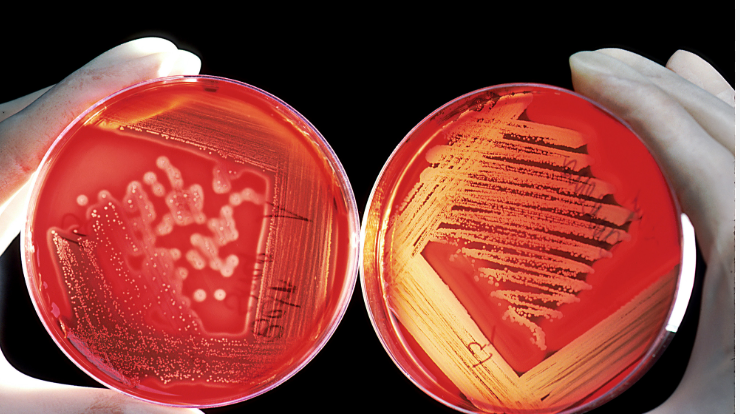

A Placa de Petri: Uma Janela para o Micromundo
A placa de Petri, um nome familiar em qualquer laboratório de biologia ou microbiologia, representa muito mais do que um simples recipiente de vidro ou plástico. É uma ferramenta engenhosa que revolucionou o estudo dos microrganismos, abrindo uma janela para um mundo invisível a olho nu e possibilitando avanços cruciais na medicina, na ciência e na indústria. Sua história está intrinsecamente ligada à própria fundação da bacteriologia como disciplina científica, marcada pela busca incessante por métodos que permitissem cultivar, isolar e observar esses seres diminutos de forma controlada e livre das contaminações que tanto frustravam os primeiros pesquisadores.
O Caminho Até a Invenção: Desafios no Cultivo Microbiano
A história das placas de Petri começa antes mesmo de sua concepção, nos desafios enfrentados pelos pioneiros da microbiologia. Em meados do século XIX, cientistas como Louis Pasteur já demonstravam a existência de microrganismos e seu papel em processos como a fermentação e doenças, mas cultivá-los em laboratório era uma tarefa árdua. Pasteur, por volta de 1860, utilizava meios de cultura líquidos, semelhantes a caldos nutritivos, acondicionados em balões de vidro com pescoços longos e curvos (os famosos "pescoços de cisne") ou em tubos de ensaio tampados com algodão. Embora esses métodos fossem inovadores para a época e permitissem demonstrar a inexistência da geração espontânea, eles apresentavam limitações significativas. A manutenção de condições estritamente assépticas era difícil, e os meios líquidos não permitiam a separação física de diferentes tipos de microrganismos presentes em uma amostra, tornando o isolamento de culturas puras um obstáculo considerável.
Robert Koch, outra figura monumental na história da bacteriologia e futuro ganhador do Prêmio Nobel, reconheceu a necessidade crítica de métodos de cultivo mais eficazes para provar a relação causal entre microrganismos específicos e doenças. Koch e sua equipe, em Berlim, buscaram alternativas aos meios líquidos. Inicialmente, recorreram a superfícies sólidas naturais, como fatias de batata cozida e esterilizada. A superfície sólida permitia que as bactérias crescessem em colônias separadas, um avanço importante. Contudo, a opacidade da batata dificultava a visualização de colônias pequenas ou pouco pigmentadas.
A busca por um meio sólido e transparente levou Koch a experimentar a adição de gelatina aos caldos nutritivos. Essa mistura, quando resfriada, solidificava, criando um meio translúcido. Koch espalhava essa gelatina em placas de vidro planas, que eram então cobertas com redomas de vidro para proteger contra a contaminação. Esse arranjo, conhecido como "placa de Koch", representou um progresso, mas ainda era imperfeito. A gelatina possuía um ponto de fusão baixo, liquefazendo-se em temperaturas de incubação necessárias para muitos patógenos, e era digerida por certas bactérias. Além disso, a manipulação sob a redoma ainda era complexa e o risco de contaminação ao levantar a cobertura para observação persistia.
Foi nesse cenário de busca por aprimoramentos que a solução definitiva começou a tomar forma, graças à contribuição de membros da equipe de Koch e, finalmente, à invenção de Julius Richard Petri.
Julius Richard Petri e a Criação da Placa
A invenção que levaria seu nome para sempre na história da ciência foi concebida por Julius Richard Petri (1852-1921). Nascido em Barmen, Alemanha, Petri seguiu uma carreira médica e militar, formando-se em medicina em 1876. Entre 1877 e 1879, enquanto servia como médico militar, foi designado para trabalhar no Gabinete Imperial de Saúde (Kaiserliches Gesundheitsamt) em Berlim, onde se tornou assistente no laboratório de Robert Koch.
No laboratório de Koch, Petri vivenciou diretamente as dificuldades associadas aos métodos de cultivo existentes. Uma inovação crucial que precedeu a invenção de Petri foi a introdução do ágar-ágar como agente solidificante, sugerida por Angelina Hesse, esposa de Walther Hesse, outro assistente de Koch. O ágar, um polissacarídeo derivado de algas marinhas, mostrou-se superior à gelatina: solidificava em temperaturas mais altas, não era digerido pela maioria das bactérias e permanecia sólido nas temperaturas ideais de incubação.
Com o problema do meio de cultura solidificante resolvido pelo ágar, Petri voltou sua atenção para o recipiente. Ele idealizou um sistema que fosse simples, eficaz na prevenção da contaminação, permitisse a troca gasosa necessária para o crescimento microbiano e facilitasse a observação. Sua solução, publicada em 1887 no artigo "Eine Kleine Modification des Koch'schen Plattenverfahrens" (Uma Pequena Modificação do Método de Placas de Koch), consistia em duas placas circulares rasas de vidro, com diâmetros ligeiramente diferentes. A placa de menor diâmetro (a base) continha o meio de cultura solidificado, e a placa de maior diâmetro (a tampa) encaixava-se sobre a base. Este design permitia que o ar circulasse pela pequena fresta entre a base e a tampa, mas impedia que poeira e microrganismos transportados pelo ar caíssem diretamente sobre a superfície do meio. A transparência do vidro permitia a observação direta das colônias em crescimento, inclusive ao microscópio, sem a necessidade de remover a tampa, minimizando drasticamente o risco de contaminação.
Embora houvesse relatos anteriores de recipientes semelhantes por outros pesquisadores como Emanuel Klein e Percy Frankland, a versão de Petri destacou-se pela sua simplicidade, praticidade e eficácia inigualáveis. A "placa de Petri", como ficou universalmente conhecida, foi rapidamente adotada por laboratórios em todo o mundo. Sua introdução foi um marco, tornando o isolamento de culturas puras uma técnica rotineira e confiável, o que foi essencial para a identificação de inúmeros agentes causadores de doenças, incluindo o bacilo da tuberculose, descoberto por Koch.
Após seu período crucial no laboratório de Koch, Petri continuou sua carreira em saúde pública e higiene, falecendo em 1921, mas sua invenção perdura como um testemunho de sua engenhosidade e um pilar da prática microbiológica.
Evolução e Aplicações Atuais: Mais de um Século de Relevância
Desde sua invenção, a placa de Petri passou por algumas evoluções, principalmente no material de fabricação. Embora as placas de vidro borossilicato reutilizáveis ainda sejam usadas por sua durabilidade e resistência térmica e química, as placas de plástico (principalmente poliestireno) descartáveis e pré-esterilizadas tornaram-se extremamente populares. Elas oferecem conveniência, eliminam a necessidade de limpeza e esterilização pós-uso e reduzem o risco de quebra e contaminação cruzada. Pequenos aprimoramentos no design, como anéis de empilhamento e marcas de ventilação para controlar a condensação, também foram incorporados. Placas com divisórias internas também estão disponíveis para testes comparativos.
Apesar dessas modificações, a função essencial e a relevância da placa de Petri permanecem inalteradas, e suas aplicações atuais são vastas e diversificadas, estendendo-se muito além da bacteriologia clássica.
Sua aplicação primordial continua sendo o cultivo de microrganismos (bactérias, fungos, leveduras). Em microbiologia clínica, ambiental, alimentar e industrial, as placas são indispensáveis para isolar, quantificar (contagem de colônias), caracterizar (observação da morfologia colonial) e manter culturas microbianas. O isolamento em placa é frequentemente o primeiro passo para identificar um patógeno em uma amostra clínica ou verificar a qualidade microbiológica de alimentos e água.
Os testes de sensibilidade a antimicrobianos (antibiogramas) são outra aplicação clínica crucial. Ao expor um microrganismo cultivado em placa a discos contendo diferentes antibióticos, os médicos podem determinar quais medicamentos serão eficazes no tratamento de uma infecção específica.
A cultura de células eucarióticas, tanto animais quanto vegetais, representa um campo de aplicação em expansão. As placas de Petri fornecem uma superfície tratada que permite a adesão e o crescimento de células em monocamada, sendo fundamentais para pesquisa básica em biologia celular, virologia (cultivo de vírus), toxicologia (teste de citotoxicidade de compostos), desenvolvimento de fármacos, engenharia de tecidos e produção de biofármacos e vacinas. Recentemente, ganharam destaque na pesquisa de carne cultivada em laboratório.
Na biologia molecular e genética, as placas são usadas rotineiramente para a seleção de bactérias geneticamente modificadas (por exemplo, após transformação com plasmídeos contendo genes de resistência a antibióticos), clonagem de DNA e estudos de mutação.
O controle de qualidade microbiológico é vital em inúmeras indústrias. Empresas farmacêuticas, de cosméticos, de alimentos e bebidas utilizam placas de Petri para monitorar a contaminação em matérias-primas, produtos acabados, ambientes de produção e sistemas de água, garantindo a segurança e a conformidade regulatória.
Além dessas áreas principais, as placas de Petri encontram uso em botânica (testes de germinação de sementes), parasitologia (cultivo de alguns parasitas ou estudo de pequenos invertebrados), educação (demonstrações práticas de crescimento microbiano) e até mesmo em arte (criação de padrões com microrganismos pigmentados).
A combinação de simplicidade, eficácia, versatilidade e baixo custo garante que a placa de Petri, concebida há mais de 130 anos, continue sendo uma ferramenta indispensável e onipresente na ciência moderna, uma verdadeira janela para a exploração do vasto e complexo mundo microbiano.
Referências
A Petri Lab é uma loja completa para equipar o seu laboratório com equipamentos e consumíveis de qualidade. Encontre tudo que precisa para pesquisa e análises com preços competitivos e entrega rápida para todo o Brasil.
Utilizamos cookies para que você tenha a melhor experiência em nosso site. Para saber mais acesse nossa página de Política de Privacidade